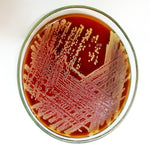

By GMP-SOP-Download Laboratory
USP 62 Absence of Staph Aureus
Regular price
£16.99 GBP
Regular price
Sale price
£16.99 GBP
Unit price
per
Tax included.
Shipping calculated at checkout.
Couldn't load pickup availability
Procedure and report form for testing the absence or presence of staphylococcus aureus in products or materials by Quality Control according to USP <62> and EP 2.6.13 and to the limits specified in USP <1111> and EP 5.1.4
Regular price
£16.99 GBP
Regular price
Sale price
£16.99 GBP